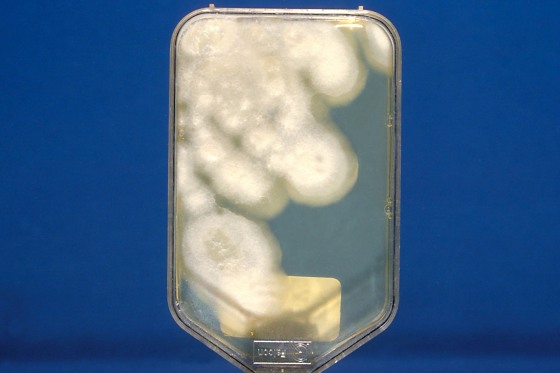
Close-up photograph of the Sebouraud dextrose agar culture of the pathogenic fungus Coccidioides immitis with chloramphenicol and cycloheximide after 2 weeks, 1979.

Fungal infections are more widespread than doctors or patients realize, research suggests. And they’re expected to grow all the more so in the coming years.
“We’re definitely seeing disease in locations that we previously have not,” said Dr. George Thompson, an infectious disease specialist at the University of California, Davis. “And that’s concerning, because if we’re recognizing those locations, where are the places it’s occurring that just have not been recognized quite yet?”
Thompson co-authored an article published Monday in the journal Annals of Internal Medicine, which suggests that more than 10% of fungal infections are diagnosed outside regions where the pathogens are known to be endemic. Plus, the paper says, misdiagnoses and a lack of data make it difficult to know how prevalent cases really are.
That’s becoming a more pressing problem, since research shows that climate change is making these infections more diffuse. For example, coccidioides, the fungus that causes Valley fever, thrives in desert climates, so increased heat and drought have created more hospitable areas for it to grow.

Meanwhile, the fungus histoplasma, which can cause an illness marked by fever, cough and fatigue, tends to survive longer in high humidity — a condition that’s also becoming more common as temperatures rise. What’s more, histoplasma is found in soil that contains large amounts of bird and bat droppings, and climate change is altering the migration patterns of some of those species.
People generally get fungal infections after breathing in spores. Often, the immune system fights these invaders off, or infections result in mild flu-like symptoms that resolve on their own. But some people — usually those with weakened immune systems — can develop life-threatening illnesses such as pneumonia or meningitis.
“The great majority of people who get Valley fever will tell you they got a cough that lasts a few weeks and it goes away,” said Dr. Arturo Casadevall, a microbiologist and immunologist at the Johns Hopkins University School of Medicine. “But when people are immunosuppressed or when they just have bad luck because they got a very large dose, these diseases can disseminate, or get outside the lung.”
Typically, different fungal infections are associated with specific regions: Valley fever is most common in the Southwest, for example, whereas histoplasmosis is mostly identified in central and eastern states. But the coccidioides fungus was found in Washington soil in 2014.
Thompson’s paper came just weeks after another study revealed high rates of fungal disease diagnoses far outside their traditionally understood geographies. The researchers found that 94% of U.S. states had at least one county with a significant number of histoplasmosis cases, and 69% had at least one county with a significant number of Valley fever cases.
“Over the last few years, I’ve started to get a lot of requests to help with these diseases,” said Andrej Spec, a co-author of that paper and infectious disease specialist at the Washington University School of Medicine in St. Louis. “Frequently, I would get a request that starts off with, ‘Interestingly enough, we don’t have this disease in Massachusetts. But here’s a patient who’s never traveled from Massachusetts and he has it, so funny thing.’ But I’m like, ‘You do have it; it’s just the maps are not up to date anymore.’”
The last study that updated geographic distributions of disease-causing fungi in the U.S. based on patient data was in 1969, according to Spec’s study.
On a global scale, a 2019 analysis determined that fungal infections were increasing and suggested that fungi may be commonly overlooked as sources of infection. A World Health Organization report in October also found that severe fungal infections became more prevalent among people with pre-existing health issues during the Covid pandemic.
Climate change isn’t the only likely factor fueling this trend, Casadevall said. Increased travel to places where fungal infections are more prevalent could play a role, and doctors may be getting better at diagnosing infections in places where they hadn’t previously been detected.
But Casadevall said many U.S. hospitals don’t report fungal infections to the CDC, and that the agency historically has not prioritized the collection of this data because fungi generally don’t cause outbreaks. The CDC received more than 20,000 reports of Valley fever and around 1,100 reports of confirmed or probable histoplasmosis in 2019.
Thompson and other infectious disease experts are calling for national surveillance of fungal infections and urging doctors to test for them more often.
Fungal infections aren’t easily picked up in routine testing, so if doctors are unaware that this could be a risk, they may not order the proper tests. The more delayed a diagnosis, the longer it takes to get a patient treated, which can result in higher medical costs and a greater chance of serious illness or death. In some cases, fungal infections can take months of treatment to clear and may become chronic.
Dr. David Denning, chief executive of Global Action for Fungal Infections, an advocacy and research group, said some rapid tests allow doctors to diagnose fungal infections within hours or minutes, but they’re not widely available in the U.S. (The standard way to test is to send a urine or blood sample to a lab, then wait several days for the result.)
“There are very few molecular tests for fungi approved by the FDA,” Denning said. “The FDA rules are pretty stringent, which is a good thing, but it’s also a bad thing because the whole of Europe is using these tests and in the U.S. there’s too much of a barrier to get these tests adopted on a routine basis.”
Many people aren’t diagnosed at all, Thompson said: “There’s probably a significant number of patients who were never diagnosed directly and really suffered a lot more morbidity from their disease.”